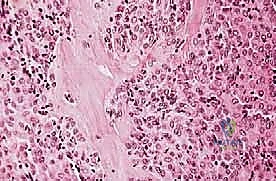
صورة توضيحية لـ دليل شامل لاستئصال الساركوما: فهم البيولوجيا، تحديد المراحل، ومبادئ الحفاظ على الأطراف مع الأستاذ الدكتور محمد هطيف

دليل شامل لاستئصال الساركوما: فهم البيولوجيا، تحديد المراحل، ومبادئ الحفاظ على الأطراف مع الأستاذ الدكتور محمد هطيف

الخلاصة الطبية
استئصال الساركوما هو إجراء جراحي حيوي لعلاج أورام العظام والأنسجة الرخوة، يعتمد على فهم دقيق لبيولوجيا الورم وتحديد مراحله لضمان إزالة كاملة مع الحفاظ على الأطراف. يقدم الأستاذ الدكتور محمد هطيف في صنعاء رعاية متكاملة ومتخصصة، من التشخيص الدقيق إلى الجراحة المتقدمة وإعادة التأهيل، لتحقيق أفضل النتائج للمرضى.
الخلاصة الطبية السريعة: استئصال الساركوما هو إجراء جراحي دقيق ومعقد يُعد حجر الزاوية في علاج أورام العظام والأنسجة الرخوة. يعتمد النجاح في هذا المجال على فهم عميق لبيولوجيا الورم، وتحديد مراحله بدقة متناهية، وتطبيق أحدث مبادئ "جراحة الحفاظ على الأطراف" (Limb-Salvage Surgery). يقدم الأستاذ الدكتور محمد هطيف، أستاذ جراحة العظام بجامعة صنعاء واستشاري جراحة العظام والمفاصل والأورام، رعاية طبية متكاملة في اليمن. بفضل خبرة تتجاوز 20 عاماً، واعتماده على تقنيات الجراحة الميكروسكوبية، ومناظير المفاصل 4K، والمفاصل الصناعية المعقدة، يضمن الدكتور هطيف تحقيق أعلى معدلات الاستئصال الجذري للورم مع الحفاظ على وظيفة الطرف، مستنداً إلى أمانة طبية صارمة وموثوقية لا تُضاهى.



مقدمة شاملة: ثورة جراحة الساركوما ومبادئ الحفاظ على الأطراف
تُعد الساركوما (Sarcoma) واحدة من أكثر الأورام الخبيثة تعقيداً وتحدياً في عالم الطب. إنها أورام نادرة تنشأ في العظام والأنسجة الرخوة (مثل العضلات، الدهون، الأوعية الدموية، والأعصاب). لعقود طويلة، كان التشخيص بالساركوما يعني في الغالب خياراً واحداً مأساوياً: البتر. ولكن مع التقدم المذهل في الطب الحديث، وتطور تقنيات التصوير، والعلاج الكيميائي، والبراعة الجراحية، تغيرت قواعد اللعبة تماماً.


اليوم، أصبح الهدف الأساسي والأسمى في علاج هذه الأورام هو "الحفاظ على الأطراف" (Limb Salvage). هذا النهج لا يقتصر على إزالة الورم فحسب، بل يمتد إلى إعادة بناء الطرف وظيفياً وجمالياً لضمان عودة المريض إلى حياته الطبيعية. يتطلب هذا النهج جراحاً يتمتع بمهارات استثنائية، يجمع بين دقة جراح الأورام، وبراعة جراح التجميل (في الجراحات الميكروسكوبية)، وخبرة جراح المفاصل. وهنا يبرز اسم الأستاذ الدكتور محمد هطيف كأحد أهم رواد هذا التخصص الدقيق في العاصمة صنعاء واليمن بأكمله.



الأستاذ الدكتور محمد هطيف: المرجعية الأولى لجراحة أورام العظام في اليمن
عندما يتعلق الأمر بأورام العظام المعقدة، فإن اختيار الجراح يحدد مصير الطرف، بل ومصير حياة المريض. يمثل الأستاذ الدكتور محمد هطيف قمة الهرم الطبي الأكاديمي والعملي في هذا المجال. بصفته أستاذاً لجراحة العظام في جامعة صنعاء، فهو لا يمارس الطب فحسب، بل يُخرّج أجيالاً من الجراحين.
- خبرة تتجاوز العقدين: أكثر من 20 عاماً من التعامل مع الحالات المستعصية وأورام العظام النادرة.
- تكامل التخصصات: يجمع بين جراحة العظام، استئصال الأورام، الجراحة الميكروسكوبية، وتركيب المفاصل الصناعية المعقدة.
- التكنولوجيا الحديثة: استخدام مناظير 4K، وتخطيط الجراحة ثلاثي الأبعاد لضمان استئصال الورم بهوامش آمنة (Negative Margins).
- الأمانة الطبية: تقييم دقيق وشفاف لحالة المريض، وتقديم الخيارات الجراحية التي تضع مصلحة المريض وحياته في المقام الأول.




فهم بيولوجيا الساركوما: العظام والأنسجة الرخوة
لفهم كيفية استئصال الساركوما، يجب أولاً فهم طبيعتها البيولوجية. تنقسم الساركوما بشكل رئيسي إلى قسمين:
1. ساركوما العظام (Bone Sarcomas)
تنشأ في العظام نفسها وتصيب غالباً الأطفال والشباب. من أشهر أنواعها:
* الساركوما العظمية (Osteosarcoma): الأكثر شيوعاً، تظهر عادة حول الركبة (أسفل الفخذ أو أعلى القصبة).
* ساركوما إيوينغ (Ewing Sarcoma): تصيب غالباً العظام الطويلة والحوض.
* الساركوما الغضروفية (Chondrosarcoma): تنشأ في الخلايا الغضروفية وتصيب البالغين وكبار السن.
2. ساركوما الأنسجة الرخوة (Soft Tissue Sarcomas)
تنشأ في الأنسجة الداعمة المحيطة بالعظام. تشمل:
* ساركوما الخلايا الزليليّة (Synovial Sarcoma).
* الساركوما الشحمية (Liposarcoma).
* الساركوما العضلية الملساء (Leiomyosarcoma).
تتميز هذه الأورام بقدرتها على اختراق الأنسجة المجاورة وتكوين ما يُعرف بـ "المنطقة التفاعلية" (Reactive Zone) أو الكبسولة الكاذبة، والتي تحتوي غالباً على خلايا سرطانية مجهرية. هذا المفهوم البيولوجي هو ما يوجه الدكتور محمد هطيف في تحديد مدى الاستئصال الجراحي.




الأسباب وعوامل الخطر: من هو المعرض للإصابة؟
رغم أن السبب المباشر لمعظم أنواع الساركوما غير معروف بدقة، إلا أن الأبحاث الطبية حددت عدة عوامل تزيد من خطر الإصابة:
* الطفرات الجينية الموروثة: مثل متلازمة لي-فراوميني (Li-Fraumeni syndrome) والورم الأرومي الشبكي (Retinoblastoma).
* التعرض السابق للإشعاع: المرضى الذين تلقوا علاجاً إشعاعياً لأنواع أخرى من السرطان.
* أمراض العظام المزمنة: مثل مرض باجيت (Paget's disease) الذي يصيب العظام عند كبار السن.
* التورم اللمفاوي المزمن: والذي قد يؤدي إلى ساركوما الأوعية اللمفاوية (Lymphangiosarcoma).

الأعراض السريرية: متى يجب زيارة الطبيب فوراً؟
التشخيص المبكر هو مفتاح الحفاظ على الطرف. يشدد الأستاذ الدكتور محمد هطيف على ضرورة الانتباه للأعراض التالية:
1. ألم العظام المستمر: ألم يزداد ليلاً ولا يتحسن مع المسكنات العادية أو الراحة.
2. كتلة أو تورم: ظهور ورم محسوس يزداد في الحجم تدريجياً، سواء كان مؤلماً أو غير مؤلم.
3. الكسور المرضية: حدوث كسر في العظم نتيجة إصابة طفيفة جداً لا تسبب كسراً في العظم السليم.
4. تحدد الحركة: صعوبة في تحريك المفصل القريب من الورم.



جدول 1: مقارنة بين أورام العظام الحميدة والخبيثة (الساركوما)
| وجه المقارنة | الأورام الحميدة (Benign) | الأورام الخبيثة / الساركوما (Malignant) |
|---|---|---|
| معدل النمو | بطيء جداً | سريع وعدواني |
| طبيعة الألم | غالباً لا يوجد ألم (إلا إذا ضغط على عصب) | ألم مستمر، يزداد ليلاً، لا يستجيب للراحة |
| حدود الورم في الأشعة | واضحة، محددة بدقة (Sclerotic margin) | غير واضحة، متآكلة (Moth-eaten appearance) |
| اختراق قشرة العظم | نادر جداً | شائع جداً، يمتد للأنسجة الرخوة المحيطة |
| الانتشار (النقائل) | لا تنتشر لأعضاء أخرى | تنتشر غالباً إلى الرئتين أو عظام أخرى |
| العلاج الأساسي | المراقبة أو الاستئصال البسيط | علاج كيميائي + استئصال جذري بهوامش واسعة |

تحديد مراحل الورم (Staging): نظام Enneking
تحديد مرحلة الورم هو الخطوة الأهم قبل أي تدخل جراحي. يعتمد الدكتور هطيف على نظام (Enneking) لتحديد مراحل أورام العظام، والذي يعتمد على ثلاثة عوامل:
1. درجة الورم (Grade - G): بناءً على الفحص النسيجي (G1 منخفض الدرجة، G2 عالي الدرجة).
2. الموقع (Site - T): هل الورم داخل الحيز العظمي (Intracompartmental - T1) أم اخترق القشرة وخرج للحيز الخارجي (Extracompartmental - T2)؟
3. الانتشار (Metastasis - M): هل انتقل الورم لأعضاء أخرى (M0 لا يوجد، M1 يوجد انتشار)؟
بناءً على هذا التقييم الدقيق، يتم وضع خطة جراحية متكاملة لضمان استئصال الورم بالكامل دون ترك أي خلايا سرطانية.




مبادئ الاستئصال الجراحي: الهوامش الجراحية (Surgical Margins)
الهدف الأول في جراحة الساركوما ليس فقط إزالة الكتلة المرئية، بل استئصالها مع طبقة من الأنسجة السليمة المحيطة بها لضمان عدم ترك أي خلايا مجهرية. تُصنف الهوامش الجراحية إلى:
- الاستئصال داخل الورم (Intralesional): يتم قطع الورم من الداخل. غير مقبول في الساركوما الخبيثة.
- الاستئصال الهامشي (Marginal): الاستئصال عبر الكبسولة الكاذبة للورم. يحمل خطر عودة الورم (Recurrence).
- الاستئصال الواسع (Wide Resection): وهو المعيار الذهبي. يتم استئصال الورم مع طبقة من الأنسجة السليمة المحيطة به (العضلات، العظام). هذا ما يبرع فيه الدكتور هطيف لضمان الشفاء التام.
- الاستئصال الجذري (Radical Resection): استئصال كامل الحيز العضلي أو العظمي الذي يحتوي على الورم.




جراحة الحفاظ على الأطراف (Limb-Salvage Surgery): الفن والعلم
تعتبر جراحة الحفاظ على الأطراف معجزة طبية حديثة. بدلاً من بتر الطرف المصاب، يقوم الأستاذ الدكتور محمد هطيف بإزالة الورم بالكامل ثم إعادة بناء العظم والمفصل والأنسجة الرخوة. تتكون هذه العملية المعقدة من ثلاث مراحل أساسية:
المرحلة الأولى: استئصال الورم (Resection)
يتم فتح الجلد والأنسجة بعناية فائقة. التحدي الأكبر هنا هو فصل الورم عن الأوعية الدموية والأعصاب الرئيسية المغذية للطرف. يستخدم الدكتور هطيف تقنيات الجراحة الميكروسكوبية لضمان سلامة هذه الهياكل الحيوية، مما يحافظ على حيوية الطرف وحركته.




المرحلة الثانية: إعادة البناء العظمي (Skeletal Reconstruction)
بعد إزالة جزء من العظم (أو المفصل بأكمله)، يجب سد الفجوة. تتعدد الخيارات التقنية التي يوفرها الدكتور هطيف في صنعاء:
1. المفاصل الصناعية الكبيرة (Megaprostheses): مفاصل معدنية متطورة (من التيتانيوم) تُصمم خصيصاً لتعويض العظم المفقود، وتسمح للمريض بالحركة المبكرة.
2. الطعوم العظمية (Bone Grafts): استخدام عظم من بنك العظام (Allograft) أو من المريض نفسه (Autograft)، مثل نقل عظمة الشظية مع أوعيتها الدموية لضمان التئامها السريع.
3. إعادة تدوير العظم (Bone Recycling): في بعض الحالات، يتم استئصال العظم المصاب، وتعقيمه بالإشعاع أو النيتروجين السائل لقتل الخلايا السرطانية، ثم إعادته للجسم.




المرحلة الثالثة: تغطية الأنسجة الرخوة (Soft Tissue Coverage)
لا تنجح العملية إذا لم يتم تغطية العظم أو المفصل الصناعي بأنسجة حيوية قوية لمنع العدوى. يستخدم الدكتور هطيف سديلات عضلية (Muscle Flaps) يتم نقلها من مناطق أخرى في الجسم لتغطية منطقة الجراحة، مع ترقيع الجلد لتحقيق أفضل نتيجة تجميلية ووظيفية.




جدول 2: مقارنة بين طرق إعادة البناء العظمي بعد استئصال الساركوما
| طريقة إعادة البناء | المزايا (Pros) | العيوب والتحديات (Cons) | الحالات الأنسب لها |
|---|---|---|---|
| المفاصل الصناعية (Megaprostheses) | استعادة الحركة فوراً، تأهيل سريع، لا تحتاج لانتظار التئام العظم | قد ترتخي مع مرور السنوات، تكلفة أعلى، عرضة للالتهابات | كبار السن، الأورام القريبة جداً من المفاصل (الركبة/الكتف) |
| الطعوم العظمية الحيوية (Biological Grafts) | تندمج مع الجسم للأبد، لا تحتاج لتغيير مستقبلي، أقل عرضة للارتخاء | تحتاج وقتاً طويلاً للالتئام، تتطلب حماية للطرف لفترة أطول | الشباب والأطفال، الأورام في منتصف العظام الطويلة (Diaphysis) |
| نقل عظمة الشظية الدموية (Vascularized Fibula) | التئام سريع جداً بسبب التروية الدموية، مقاومة للعدوى | جراحة ميكروسكوبية معقدة وطويلة، ألم في مكان أخذ العظمة | الفجوات العظمية الكبيرة جداً، حالات الالتهابات السابقة |

التقنيات الحديثة في غرفة العمليات مع الدكتور هطيف
التميز في جراحة الأورام يتطلب مواكبة أحدث التطورات التكنولوجية العالمية. في اليمن، يقدم الدكتور محمد هطيف معايير عالمية من خلال:
- التخطيط الجراحي ثلاثي الأبعاد (3D Pre-operative Planning): يتم تحويل صور الأشعة المقطعية والرنين المغناطيسي إلى مجسمات ثلاثية الأبعاد، مما يسمح للجراح بالتخطيط الدقيق لخطوط القطع قبل دخول غرفة العمليات.
- مناظير المفاصل 4K: في حالات تشخيص أورام المفاصل أو أخذ العينات، توفر هذه التقنية رؤية فائقة الدقة لتجنب نشر الخلايا السرطانية.
- الجراحة الميكروسكوبية (Microsurgery): لخياطة الأوعية الدموية والأعصاب الدقيقة التي لا تُرى بالعين المجردة، مما يضمن تدفق الدم للطرف بعد الاستئصال الواسع.






دور العلاج الكيميائي والإشعاعي المتكامل (Multidisciplinary Approach)
جراحة الساركوما لا تتم بمعزل عن التخصصات الأخرى. يعمل الدكتور هطيف ضمن فريق طبي متكامل (Tumor Board).
* العلاج الكيميائي قبل الجراحة (Neoadjuvant Chemotherapy): يُعطى لتصغير حجم الورم، مما يسهل عملية الحفاظ على الطرف، ويقتل الخلايا السرطانية الدقيقة المنتشرة في الدم.
* العلاج الإشعاعي (Radiotherapy): يُستخدم غالباً في ساركوما الأنسجة الرخوة لتقليل احتمالية عودة الورم موضعياً.
يتم تقييم مدى استجابة الورم للعلاج الكيميائي (Tumor Necrosis Rate) بعد الاستئصال، وهو مؤشر قوي لفرص الشفاء التام.





إعادة التأهيل الشامل: طريق العودة إلى الحياة الطبيعية
عملية استئصال الساركوما هي نصف المعركة، النصف الآخر يكمن في إعادة التأهيل. يضع الدكتور هطيف بروتوكولاً صارماً للعلاج الطبيعي يبدأ من اليوم الأول بعد الجراحة:
- المرحلة الأولى (أول أسبوعين): التركيز على التئام الجروح، السيطرة على الألم، والبدء بحركات بسيطة سلبية لمنع تيبس المفاصل.
- المرحلة الثانية (من أسبوعين إلى 6 أسابيع): البدء بالتحميل الجزئي على الطرف (إذا سمح نوع إعادة البناء بذلك)، وتقوية العضلات المحيطة.
- المرحلة الثالثة (بعد 6 أسابيع فصاعداً): تدريبات التوازن، المشي المستقل، والعودة التدريجية للأنشطة اليومية.
الدعم النفسي لا يقل أهمية عن العلاج الجسدي، حيث يحرص الدكتور هطيف وفريقه على تقديم الدعم المعنوي للمريض لتجاوز صدمة التشخيص بالسرطان وتحديات فترة النقاهة.






قصص نجاح: إشراقة أمل من عيادة الدكتور هطيف
تزخر مسيرة الأستاذ الدكتور محمد هطيف بالعديد من الحالات المعقدة التي كانت على وشك البتر، وتم إنقاذها بفضل الله ثم بفضل مهارته الجراحية.
الحالة الأولى: إنقاذ ساق شاب رياضي
شاب في العشرينيات عانى من ساركوما عظمية في أسفل عظمة الفخذ. كان التشخيص المبدئي في مراكز أخرى هو البتر. بفضل التقييم الدقيق، أجرى الدكتور هطيف جراحة استئصال واسع للورم مع تركيب مفصل ركبة صناعي مخصص للأورام (Tumor



















آلام العظام والمفاصل وتقييد حركتها ليس قدراً محتوماً! التشخيص الدقيق والعلاج المتخصص يمكن أن يعيد لك كامل وظيفتك وحريتك في الحركة. لا تدع الألم يسيطر على حياتك.
للحصول على استشارة دقيقة وخطة علاجية مخصصة لحالتك، تواصل فوراً مع مركز الأستاذ الدكتور محمد هطيف:
الأستاذ الدكتور محمد هطيف - أفضل دكتور عظام في صنعاء، وخبير في جراحات العظام والمفاصل والعمود الفقري.. نلتزم بإعادتك لحياة خالية من الألم وحركة طبيعية.
مواضيع أخرى قد تهمك


